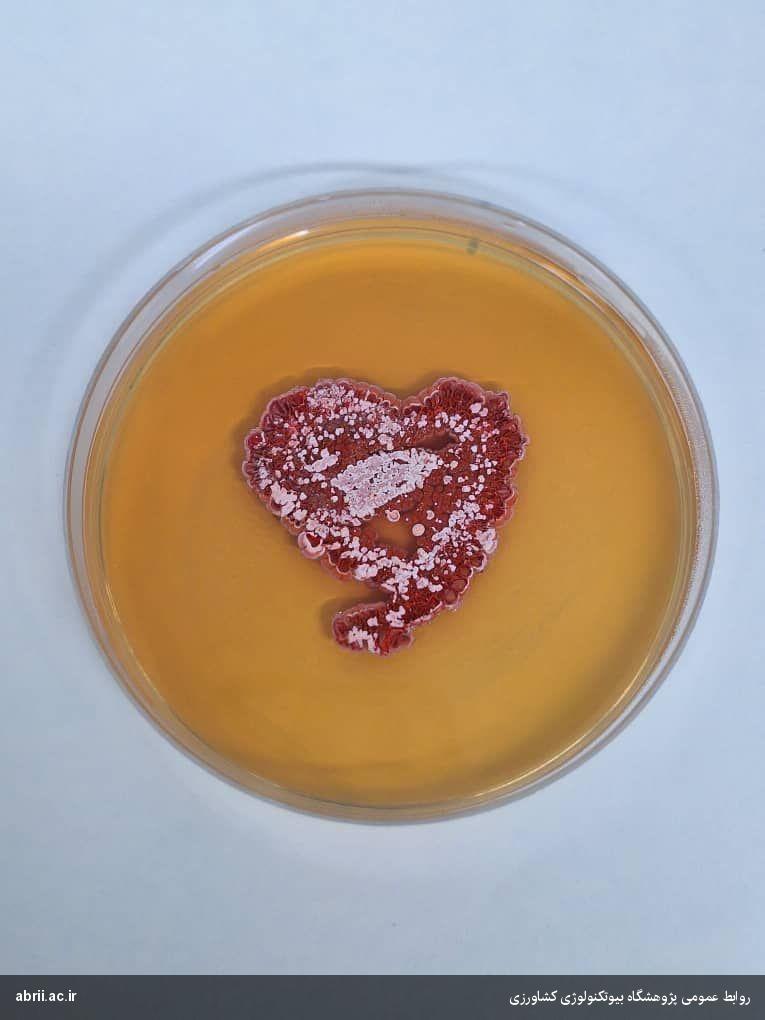
img-2

معرفی «فیدبک»، نخستین کود زیستی اکتینومیستی ایرانی برای افزایش عملکرد، کیفیت و ماندگاری گوجهفرنگی
با تجاری سازی نخستین کود زیستی اکتینومیستی ویژه گوجه فرنگی که به همت عضو هیات علمی پژوهشگاه بیوتکنولوژی کشاورزی تولید شده، زمینه ارتقای عملکرد، کیفیت و ماندگاری گوجه فرنگی و کاهش ضایعات این محصول در کشور فراهم شد. به گزارش روابط عمومی پژوهشگاه بیوتکنولوژی کشاورزی، کود زیستی فیدبک که با توجه به نیاز کشاورزان و صادرکنندگان کشور تولید شده، نخستین کود زیستی اکتینومیستی ویژه گوجه فرنگی است که مجوزهای لازم را از موسسه تحقیقات خاک و آب نیز کسب کرده است. این کود زیستی که حاصل اجرای پروژه های تحقیقاتی و ترویجی از سال ۱۳۹۴ تا ۱۴۰۳ است مورد استقبال کشاورزان و گلخانه داران گوجه فرنگی قرار گرفته است. اکرم صادقی، عضو هیات علمی پژوهشگاه بیوتکنولوژی کشاورزی که هدایت این تحقیقات را عهده دار بوده اظهار داشت: تحقیقات و ارزیابیهای این طرح از ابتدا بر پایه دانش بومی و با بهرهگیری از دقیق ترین ابزارهای شناسایی مولکولی انجام شده و کود تولیدی که نخستین کود زیستی اکتینومیستی تولید شده مخصوص گوجه فرنگی در کشور است بارها در سطح پایلوت ارزیابی شده است. پس از بررسی و حصول اطمینان از کیفیت گوجه فرنگی تولیدی با این کود از لحاظ محتوای باقیمانده نیترات، مواد مغذی، عطر و طعم، بازارپسندی و ماندگاری محصول در سردخانه، یافته ها و نتایج در قالب برنامه روز مزرعه به گلخانه داران پیشرو و کارشناسان ترویج جهاد کشاورزی استان البرز ارائه شده است. شکوری، مدیرعامل شرکت زرین مهد فیدار نیز که طی قراردادی با پژوهشگاه بیوتکنولوژی کشاورزی مجوز استفاده از دانش فنی تولید این کود زیستی را کسب کرده است گفت: کود زیستی فیدبک به سفارش شرکت زرین مهد توسط شرکت پایا زیست مکمل (اکتینو) تولید شده و بر پایه تحقیقات انجام شده، نتایج استفاده از این کود بسیار رضایتبخش و فراتر از انتظار بوده و شاهد بهبودی قابل توجه در شاخصهاي رشد، سلامت بوته و کیفیت محصول بودیم که این امر مورد استقبال و تحسین کارشناسان و بهره برداران محلی قرار گرفته است. شاهی مدیر عامل شرکت پایا زیست مکمل در ادامه توضیح داد که فیدبک اولین کود زیستی اکتینومیستی تولید شده بر پایه تخمیر بستر جامد در ایران و در نوع خود بی نظیر است.